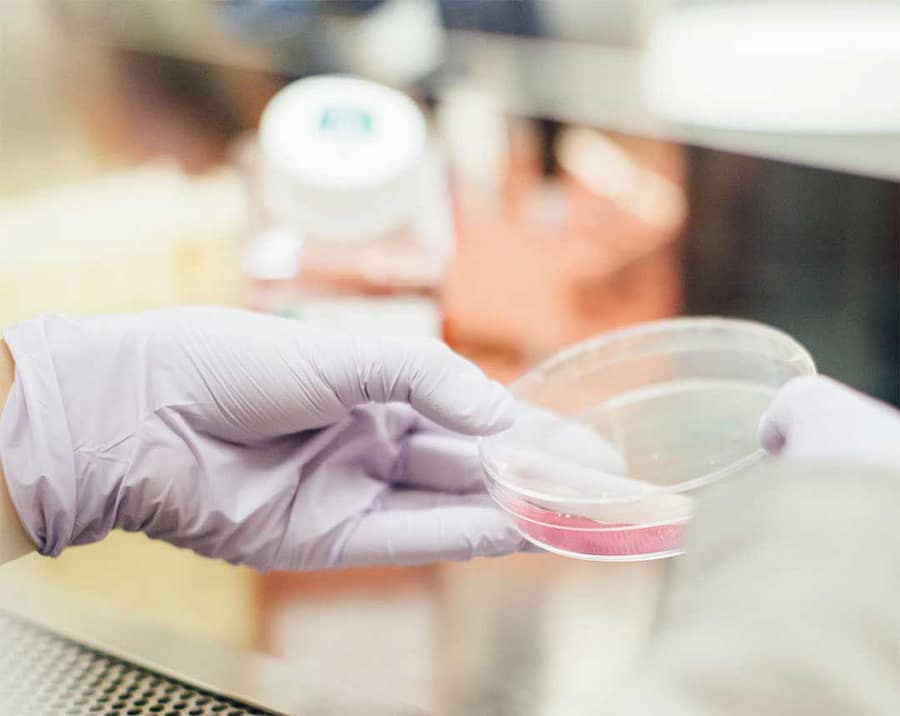
Graviola funciona com todos os tipos de tumores?

Atualmente, existem numerosos estudos que provam que a Graviola é um suplemento extremamente eficaz utilizado juntamente com o tratamento habitual para combater o cancro do pâncreas. As suas numerosas propriedades, entre as quais a capacidade de se alimentar de células cancerosas, contribuem significativamente para reduzir e até mesmo eliminar os tumores. Recomendamos tomar “Graviola Prozono“
Encontra os estudos abaixo
- O Extrato de Folha de Annona muricata Desencadeou a Via Apoptótica Intrínseca para Atenuar as Características Cancerosas das Células do Cancro da Mama Triplo Negativas MDA
- Estudos sobre o uso de Graviola no Cancro do Pâncreas (Espanhol)
O que é que devo saber sobre o cancro do pâncreas?
O cancro do pâncreas é um dos mais agressivos devido ao facto do diagnóstico precoce ser muito complicado. No entanto, tentaremos dizer-te de uma forma fácil de compreender o que podes fazer para o prevenir, detetar ou combater, se alguma vez o tiveres.
Prevenção
Como acontece com qualquer cancro, não há nenhum método que possa evitar o seu surgimento a 100%. No entanto, viver um estilo de vida saudável, fazer exercício físico com uma boa nutrição, evitar álcool, tabaco e excesso de peso, são coisas que estão ao nosso alcance e que podem reduzir as hipóteses de sofrer de cancro do pâncreas.
Também deves considerar a predisposição genética. Eles podem ser evitados, mas se houver vários casos na tua família, deves mencioná-los ao teu médico para que ele possa realizar o teste genético relevante.
Causas
Neste tipo de cancro existem muitas incógnitas relacionadas às causas de maior incidência que podem originá-lo… Os fatores genéticos e o tabagismo parecem ser os dois fatores mais conhecidos.
Sintomas
Em primeiro lugar, o cancro do pâncreas não apresenta geralmente sintomas nas fases iniciais, razão pela qual é tão difícil de ser detetado. No entanto, listamos abaixo alguns dos sintomas mais comuns neste tipo de cancro.
- Dor abdominal ou nas costas
- Cansaço e fadiga, juntamente com perda de apetite, náuseas e vómitos
- Coágulos de sangue, geralmente nas pernas
Tipos
Existem vários tipos que se diferenciam dependendo se o cancro começou no componente exócrino ou endócrino. Existem tipos de tumores que não podem ser classificados num tipo específico. No entanto, listamos – brevemente – os dois tipos mais comuns:
- Tumores exócrinos Geralmente este tipo de tumor começa a desenvolver-se nos ductos pancreáticos. São o tipo mais comum de tumor pancreático.
- Tumores endócrinos Este tumor representa cerca de 1% dos casos de cancros do pâncreas, sendo o menos frequente neste tipo de cancro. Também são chamados de tumores de células ilhotas ou tumores neuroendócrinos pancreáticos.
Diagnóstico
Para diagnosticar o cancro do pâncreas existem vários métodos diferentes.
Métodos não invasivos são todos aqueles que permitem uma “foto” da área da próstata, mas que muitas vezes não são conclusivos. Ou seja, ultra-sons, tomografia ou ressonância magnética.
Os métodos invasivos são mais definitivos em termos de diagnóstico e os médicos usam-nos quando existem indicações de que podes estar a sofrer de cancro do pâncreas. Entre estes, encontrarás:
- Biópsias Consistem na extração de uma amostra da área afetada para análise de células cancerosas.
- Colangiopancreatografia. Existem várias maneiras de realizar este teste. Consiste basicamente em tentar observar o pâncreas por dentro, sem realizar grandes cirurgias. Pode ser feito ao inserir um tubo através da garganta enquanto o paciente está dormente ou ao injetando meios de contraste observando a reação.
- Angiografia Os vasos sanguíneos são analisados após a injeção de uma substância para verificar o seu comportamento.
Tratamentos
- Intervenção Cirúrgica Em geral, a cirurgia é realizada de acordo com pressupostos:
- Quando a evidência sugere que há possibilidades de remover completamente o cancro.
- Quando, após a propagação do cancro, a cirurgia tentará evitar outras complicações ou melhorar a qualidade de vida do paciente.
- Tratamentos de ablação ou embolização Estes são tratamentos baseados, não em extrair os tumores, mas em destruí-los. Eles são mais usados como tratamentos paliativos do que como cura, uma vez que é difícil para eles curarem o cancro pancreático por conta própria.
- Radioterapia Este tipo de tratamento consiste em submeter o pâncreas afetado à radiação de todos os tipos de raios X para eliminar possíveis células cancerosas que o cirurgião não foi capaz de ver. Também é usada, não só como uma cura, mas também para aliviar os sintomas. O seu principal efeito é a vermelhidão da pele.
- Quimioterapia É administrada por via oral ou através de injeções intramusculares ou intravenosas. Tal como a radioterapia, o seu principal objetivo é matar as células cancerosas. Os seus principais efeitos secundários são a queda de cabelo, náuseas e perda de apetite
- Outros tratamentos Há também outros tratamentos, como a terapia direcionada, que se caracteriza por administrar ao paciente um tratamento que é “treinado” para matar células cancerosas.